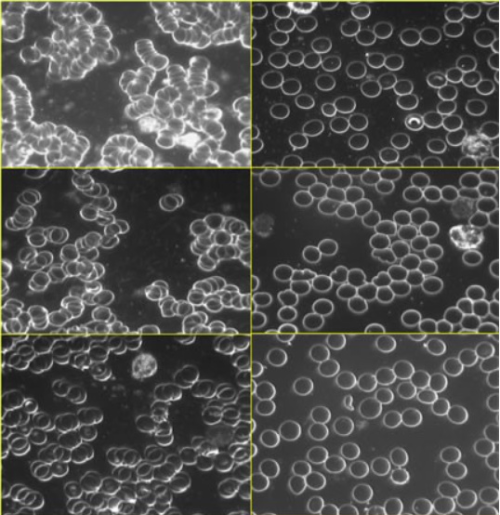

맨발 걷기가 건강에 도움이 된다는 사실이 알려지면서 큰 인기를 끌고 있습니다. 맨발로 땅과 접지하는 '어싱'을 통한 자연 치유 효과가 주목받고 있습니다.

맨발 걷기의 효과
맨발 걷기의 효과는 KBS 프로그램 '생로병사의 비밀'을 통해 방송되며 크게 주목받고 있습니다.
2023년 7월 5일 방송된 생로병사의 비밀 '맨발로 걸으면 생기는 일' 편은 맨발로 걸으면 우리 몸에 어떤 변화가 생기는지를 4주간의 관찰 실험을 통해 보여주었습니다.
프로그램에는 암 수술을 겪은 뒤 극심한 휴유증을 겪은 김현정(가명)씨와 대장암 진단 이후 건강을 찾기 위한 운동으로 맨발 걷기를 시작한 이정학 씨가 등장하고 맨발로 국내외 산을 등반하고 있는 박석주 씨의 사례도 소개됩니다. 또 포항 북구보건소가 54명의 참가자를 모집해 100일간 진행한 맨발 걷기 프로젝트의 결과도 소개됩니다.
방송은 신발을 신고 걸을 때보다 맨발로 걷는 것이 치유 효과가 있고 실제 우리 몸에 어떤 변화가 나타나는지를 다루고 있습니다.
맨발로 지구와 접지 '어싱'‥대지의 자연 치유에너지 가져오기
2013년 미국의 심장의학자인 스티븐 시나트라 박사는 대체 및 보완의학 학회지에 발표한 논문 '접지는 혈액의 점성을 묽게 한다'를 통해 맨발 걷기가 우리 몸의 혈액을 희석시키는 효과가 있다는 연구 결과를 발표했습니다.
연구 결과에 따르면 땅과의 직접 접촉을 의미하는 어싱(Earthing)활동, 맨발 걷기를 40분 한 뒤 끈적끈적한 점성이 있는 혈액이 깨끗해졌습니다. 표면 세포간 밀어내는 힘인 적혈구 제타전위(Zeta Potential)가 평균 2.7배 높아지면서 혈류 속도가 빨라졌기 때문입니다.
어싱은 땅(earth)과 현재진행형(ing)의 합성어로 지구와 우리 몸을 직접 접촉해 지표면에 존재하는 에너지를 흡수하는 행위를 통칭합니다. 우리말로는 접지(接地)라고 합니다.
어싱의 창시자로 불리는 클린턴 오버(Clinton Ober)는 2010년 다른 전문가들과 함께 펴낸 발간한 '어싱: 땅과의 접촉이 치유한다'라는 저서를 통해 맨발로 땅을 밟을 때 몸속으로 흘러드는 자유전자(음전하)가 염증과 만성질환의 원인인 활성산소(양전하)를 중화시킨다고 밝혔습니다.



그의 이론에 따르면 맨발로 땅과 접촉하는 순간 몸의 양전하가 땅의 음전하를 만나며 이온 교환이 일어나고 사람 몸의 전류는 0이 됩니다. 전류가 0이 되는 순간 우리 몸의 정전기는 빠져나가고 땅의 음전하가 발바닥을 통해 우리 몸으로 들어옵니다. 이 과정을 통해 에너지 밸런스가 맞춰지고 활성산소가 사라지며 염증 억제, 혈액순환 개선 등의 건강 효과를 기대할 수 있다는 겁니다.

맨발 걷기 국민운동본부가 회원 1,652명을 상대로 효과가 나타나기까지 걸린 시간을 설문한 결과 응답자의 41.8%가 3개월 미만이라고 응답했습니다. 응답자의 66.6%가 6개월 이내에 효과를 경험한 것으로 나타났습니다.
| 효과가 나타나기까지 맨발 걷기 기간 (맨발걷기운동본부 회원 1,652명 응답) |
|
| 3개월 미만 | 41.8% |
| 3개월 이상~6개월 미만 | 24.8% |
| 6개월 이상~1년 미만 | 16.0% |
| 1년 이상 | 12.8% |
파상풍, 당뇨환자 주의해야
맨발 걷기 바람이 불고 있지만 제대로 준비하지 않으면 오히려 건강을 해칠 수 있습니다. 신발이나 양말을 신지 않는 만큼 사전에 파상풍 예방주사를 접종하는 것이 좋습니다. 발 건강이 매우 중요한 당뇨환자는 더욱 주의가 필요합니다. 또 평지가 아닌 곳에서 무리하게 걷다 골정 등의 부상을 당할 수도 있습니다.
대한민국 맨발학교는 학교 운동장을 맨발 걷기 장소로 추전합니다. 학교 운동장은 평평해 무릎이나 관절이 좋지 않은 사람에게 좋고 발을 찔릴 위험도 적기 때문입니다. 바른 자세도 중요합니다. 양 발은 약간 넓은 평균대에서 걷는 느낌으로 11자가 되도록 하고 발뒤꿈치부터 발바닥, 엄지발가락 순으로 발 전체로 땅을 누르듯이 걷는 것이 좋습니다.
맨발 걷기가 인기를 끌면서 걷기 코스를 조성하고 지원 조례를 만드는 지자체가 잇따르고 있습니다. 드라마 촬영장으로 유명한 문경새재는 걷기 성지로도 유명합니다. 제1관문에서 제3관문에 이르는 7㎞ 구간이 부드러운 황토길로 조성돼 있습니다. 자동차 2대가 교행할 수 있을 만큼 폭도 넉넉해 걷기에 적합합니다. 지난 8월 18일~19일 이틀간 열린 문경새재 맨발페스티벌에는 전국에서 3천여 명이 참가했습니다. 이 대회는 2023년, 올해로 18회째를 맞았습니다.
| 전국 걷기 명소 | |
![]() 울산 중구 황방산 |
![]() 경북 문경새재 |
![]() 대전 계족산 |
![]() 전남 영광군 풀무산 |
![]() 금강자연휴양림 |
![]() 용인시 미사 한강 5호공원 |
![]() 논산 마음수련 명상센터 |
|
[함께 보면 좋은 글]
콤부차의 인기·효능·유래‥발효 원액 함량 중요
콤부차가 큰 인기를 끌고 있습니다. 녹차나 홍차를 우린 찻물에 복합 미생물을 넣어 발효시킨 것으로 다이어트와 간 기능 개선 등의 효능이 있습니다. 콤부차의 유래와 효능에 대해 알아봅니다.
world-curiosity.com
상병수당 2단계 ‥ 지원대상, 지급금, 신청·지급절차 정리
상병수당 2단계 시범사업이 7월부터 시행됩니다. 4곳이 새로 추가되면서 모두 10곳으로 늘어났고 대상자는 소득 하위 50% 취업자로 한정됐습니다. 지원대상과 지급금액, 신청과 지급절차 등을 정
world-curiosity.com
'알뜰 깨알 뉴스 집합' 카테고리의 다른 글
| 하마스와 가자 지구·서안 지구, 헤즈볼라 상식 정리 (0) | 2023.10.18 |
|---|---|
| 빈대(베드버그)주의보‥은신처 찾기와 제거 방법 (0) | 2023.10.17 |
| 친환경 보일러 보조금&보일러 외출 기능 사용법 (0) | 2023.10.05 |
| 2023년 단풍 시작, 국립공원 도시락 서비스 (0) | 2023.10.03 |
| 코로나19·인플루엔자 백신 동시접종‥65세 이상 10월 19일부터 (1) | 2023.09.26 |









댓글